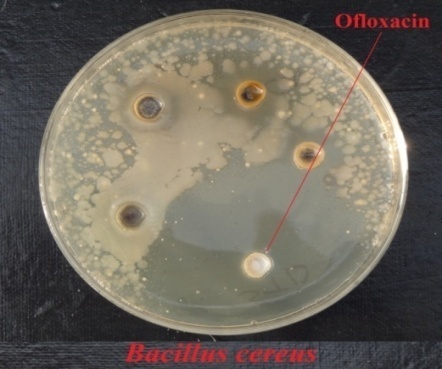
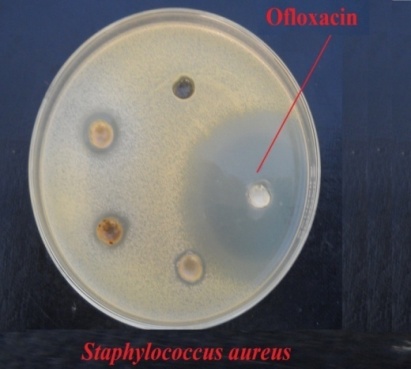
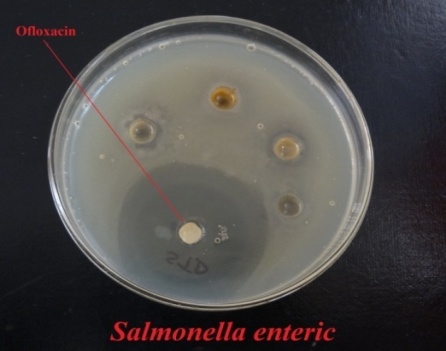
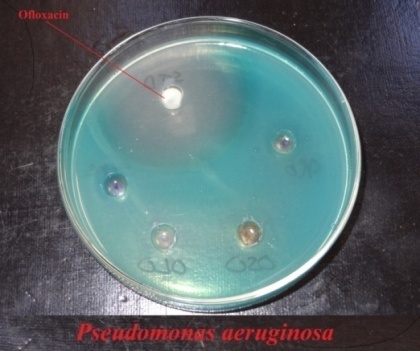
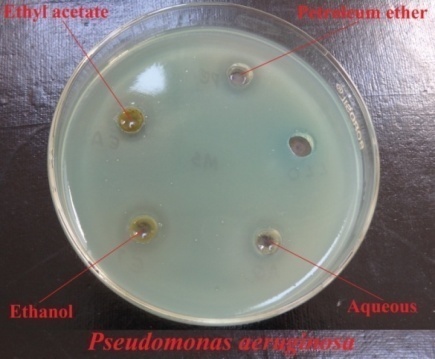
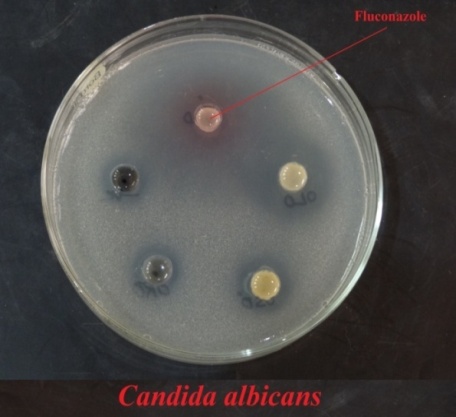
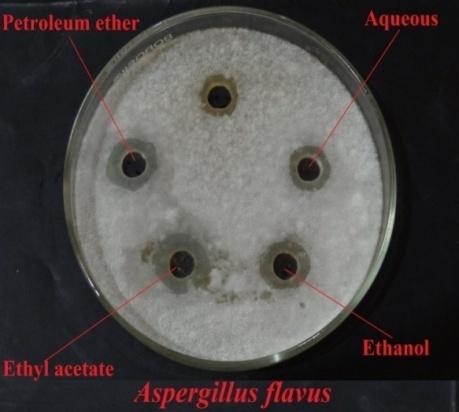
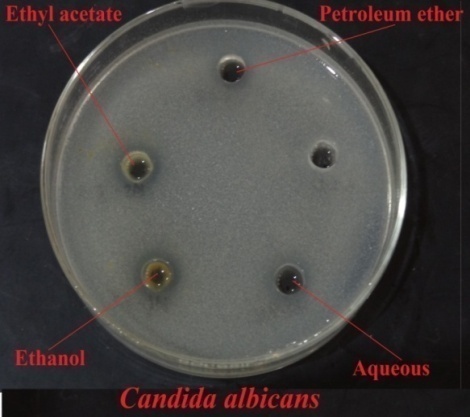

Int J Pharm Pharm Sci, Vol 7, Issue 1, 191-197Original Article
PHYSICAL EVALUATION, PROXIMATE ANALYSIS AND ANTIMICROBIAL ACTIVITY OF MORUS NIGRA SEEDS
RISHI KUMAR SHUKLA*, DEEPAK PAINULY, ABHA SHUKLA, VINEET KUMAR, JASHBIR SINGH, ANIRUDH PORVAL, SWATI VATS
1Department of Chemistry, Gurukula Kangri Vishwavidyalaya, Haridwar, Uttarakhand 249404, India , 2Department of Chemistry, Kanya Gurukula Campus, Gurukula Kangri Vishwavidyalaya, Haridwar, Uttarakhand 249407, India.
Email: rks.hdr@gmail.com
Received: 22 Oct 2014 Revised and Accepted: 20 Nov 2014
ABSTRACT
Objective: The present study investigates physical evaluation, proximate analysis, nutritive value and antimicrobial activity of Morus nigra seeds.
Methods: Physical evaluation proximate analysis and phytochemical screening of Morus nigra seeds was performed by standard protocols. Antibacterial and antifungal activity was performed by agar well diffusion method.
Results: Physical evaluation of seeds revealed the presence of 5.553 % total ash, other ash values lies within permissible limit range. Alcohol soluble and water soluble extractive values were found to be 6.561 and 5.587 % respectively. Seeds of Morus nigra contain moisture (5.356%), total nitrogen (2.886%), crude protein (18.039%), crude fat (2.907%), crude fiber (5.662%), total carbohydrate (68.145%) and available carbohydrates (62.483%). The nutritive value for seeds was calculated to be 370.899 Kcal/100 gm. Phytochemical screening revealed the presence of a number of secondary metabolites like alkaloids, terpenoids, steroids, phenolics and flavonoids. Antibacterial activity of seeds was evaluated against four bacterial strains. Antifungal activity was performed against two fungal strains. Ethyl acetate extract demonstrated prominent activity against all microbes.
Conclusion: The results demonstrated the presence of an appreciable content of fat, carbohydrate and protein which may fulfill the nutritional demand of society. Seeds of Morus nigra could also be a source of novel phytoconstituents or antimicrobial agent of herbal origin.
Keywords: Morus nigra, Physical evaluation, Proximate analysis, Antibacterial activity, Anti-fungal activity, Nutritive value.
INTRODUCTION
The use of herbal medicine for treating diseases might perhaps the oldest existing method that humanity has tried to cope with illness. For this reason, medicinal plants have been used therapeutically all around the world, being an important aspect of various traditional medicine systems. From ayurveda to Chinese traditional medicine, from Unani to Tibetan Medicine and from Amazonian to African Medicine, all systems of traditional medicine, although based on different theoretical and cultural models, amalgamate phytotherapy in to their doctrine.
Quality controls of synthetic drug offer no problems with very well defined parameters of analysis. In contrast, herbal products represent a number of unique problems when quality aspects are considered. This is so because most of the herbal medicines are in the form of crude extracts which are a complex mixture of different secondary metabolites that can vary considerably depending on environmental and genetic factors. Moreover, the constituents responsible for the claimed therapeutic effects are frequently unknown or partly explained [1]. According to WHO, quality control of herbal drugs involves estimation of foreign organic matter, ash values, moisture content, extractive values, crude fibre, crude fat, crude protein, total carbohydrate, qualitative chemical evaluation, chromatographic examination and toxicological studies [2].
Synthetic antibiotic often produces tolerance in human and creates resistance in microbes for a particular antibiotic after being continuously used for a specific time; however being synthetic they have a number of side effects over an agent of natural origin. So researchers are always in search of a drug that could be therapeutically efficacious towards a wide range of microbes with minimal or no side effects.
Morus nigra L. (Black mulberry) belongs to Moraceae. Morus nigra L. is a wildly growing rustic plant, also grown in gardens and is used in sericulture [3]. Fruits of mulberry are known by the Persian-derived name Toot (mulberry) or Shahtoot (king’s or “superior” mulberry). Black mulberries are not only consumed fresh but also used to produce jams, syrups and several types of soft drinks and traditional products such as mulberry pekmez, mulberry pestil [4]. Morus nigra fruit is nutritive, cooling, mild laxative, expectorant and used to treat sore throat, mouth lesions, melancholia, dyspepsia, allays thirst and fever. The Greeks used the plant to treat gout and named the fruit as “gout fruit.” The fruits are one of the constituents of Unani medicine named “Tut- i-aswad” which is said to be against cancer [5]. Root of this plant has an effect on pancreas and glycogenoylsis while its juice reduces the blood sugar level in diabetic patient [6]. Seeds are traditionally used to treat microbial infections, but no scientific proofs are available in this regard [7]. Till date, no work on appraisal of physical parameters, proximate analysis, nutritional value and antimicrobial activity of Morus nigra seeds has so far been cited. So the present study reveals with physical evaluation, proximate analysis, nutritional value and antimicrobial activity of seeds of this plant.
MATERIALS AND METHODS
Reagents, chemicals and microbial isolates
Hydrochloric acid, sulphuric acid (Rankem); copper sulphate, sodium sulphate, methyl red, bromocresol green (SDFCL); boric acid, sodium hydroxide (CDH); petroleum ether, chloroform, ethyl acetate, ethanol (Merck); Muller Hinton Agar, Muller Hinton broth, Sabourd dextrose agar, Sabourd dextrose broth, (Hi-media); ofloxacin (Welcure Drugs and pharma Ltd.) and fluconazole (Cipla) were purchased. All other chemicals and reagent used were of analytical or HPLC grade. Microbial strains Bacillus cereus (MTCC-1688), Staphylococcus aureus (MTCC-737), Salmonella enteric (MTCC-98), Pseudomonas aeruginosa (MTCC-430), Aspergillus flavus (MTCC-277) and Candida albicans (MTCC-227) were purchased from MTCC, Chandigarh, India.
Collection of plant material
Fruits of Morus nigra were collected from Dehradun, Uttarakhand (India) in May, 2012 and authenticated by Botanical Survey of India, Northern Regional Centre, Dehradun (BSD) under accession No. 114150. A voucher specimen has been retained in Department Of Chemistry, Gurukula Kangri Vishwavidyalaya, Haridwar under the registry No. 24/15. Collected fruits were harvested for seeds. They were washed with water to remove dirt, dried in shade and finally grinded in to powder form and stored in polythene bags for further use.
Physical evaluation
Powdered seeds were processed to undergo physical evaluation where ash value and extractive values were determined. Ash value included the estimation of total ash, acid-insoluble ash, acid-soluble ash, water-soluble ash, and sulphated ash, while the extractive value involved the estimation of alcohol-soluble and water-soluble extractive value. All the parameters were performed in triplicate according to standard pharmacopoeial methods [8].
Proximate analysis
Seeds of Morus nigra were allowed to undergo proximate analysis where they were screened for moisture content [9], total nitrogen content [10, 11], crude protein [10, 11], crude fat [12, 13], crude fiber [14], total carbohydrate content and available carbohydrate content [15]. All the parameters where performed in triplicate by standard protocols.
Nutritive value
Nutritive value of seeds was expressed in Kcal/100 gm and calculated on the basis of data of proximate analysis using general Atwater factors with the help of equation [15].
Nutritive value = (4 x % Protein) + (9 x % Crude Fat) + (4 x % Carbohydrate)
Preparation of extracts
Extraction of Morus nigra seeds was done using soxhlet apparatus. Briefly 170 gm of powdered seeds were loaded in thimble of soxhlet extractor and extracted with petroleum ether, ethyl acetate, ethanol and double distilled water in increasing order of polarity. A minimum of 75 cycles of siphoning was done for each solvent, and the process was continued for 72 hours or until the solvent in the extractor siphon tube became colourless. Extracts were concentrated at reduced pressure in a rotary vacuum evaporator and refrigerated until further use.
Phytochemical screening
Phytochemical analysis for various phytoconstituent of the extracts was undertaken using standard qualitative methods. [16, 17] The extracts were screened for the presence of biologically active compounds like alkaloids, carbohydrates, glycosides, amino acid, proteins, steroids and triterpenoids, flavonoids, phenolics and tannin, gums and mucilages, naphthoquinones etc.
Anti-microbial activity
Extracts obtained from seeds were allowed to screen for anti-bacterial and anti-fungal activity
Anti-bacterial activity
Anti-bacterial activity of Morus nigra seeds was investigated against two garm positive Bacillus cereus, Staphylococcus aureus and two gram negative bacterial strains; Salmonella enteric and Pseudomonas aeruginosa. The activity was performed by agar well diffusion method [18]. Muller Hinton Agar and Muller Hinton broth were used as culture media for the test bacterial strains. Bacterial cultures, freshly grown at 37°C in Muller Hinton Broth were appropriately diluted in sterile normal saline solution and the turbidity of the suspension was adjusted equivalent to a 0.5 McFarland standard by adding more organisms, so as to obtain the cell suspension between 105to108 CFU ml-1. 0.1 ml of diluted inoculums of test bacterial strains were mixed with melted Muller Hinton agar and subsequently spread on previously sterilized plates. Wells of 6 mm diameter were punched on each plate with a sterile cork borer. Each well was filled with 50 µl (50 mg ml-1) of extracts dissolved in DMSO. Ofloxacin (40 mg ml-1) was used as standard. Well devoid of extracts and presence of DMSO served as control. The plates were incubated for 24 hour at 37oC in a BOD incubator. Anti-bacterial activity was evaluated by measuring the zone of inhibition against the test organism. All the test process was performed in triplicate in laminar chamber. The percentage antibacterial inhibition of each extract was also calculated with respect to standard drug using the formula [19].

Where X = Zone of inhibition (in mm) by test extracts
Y = Zone of inhibition (in mm) by Control
Z = Zone of inhibition (in mm) by Standard drug.
Anti-fungal activity
Anti-fungal activity of each extract was tested against two fungal strains i. e. Aspergillus flavus and Candida albicans. Anti-fungal activity was also performed by agar well diffusion method [18]. Sabourd dextrose Agar and Sabourd dextrose broth were used as culture media for the test fungal strains. Fungal cultures, of 48-72 hours old grown on Sabourd dextrose agar were used for preparing inoculums. An aliquot (0.02 ml) of inoculum was introduced to molten Sabourd dextrose agar and poured in to previously sterilized plates by pour plate technique. After solidification, wells of 6 mm diameter were punched on each plate by using sterile cork borer. Each well was filled with 50 µl (50 mg ml-1) of extracts dissolved in DMSO. Fluconazole (40 mg ml-1) was used as standard. Well devoid of extracts and presence of DMSO served as control. The plates were incubated for 48-72 hour at 37oC in a BOD incubator. The antifungal activity was evaluated by measuring zones of inhibition of fungal growth surrounding the particular extracts and standard drug. All the test process was performed in triplicate in laminar chamber. The percentage antifungal inhibition of each extract was also calculated with respect to standard drug using the formula [19].

Where X = Zone of inhibition (in mm) by test extracts
Y = Zone of inhibition (in mm) by Control
Z = Zone of inhibition (in mm) by Standard drug.
Statistical analysis
Results were presented as mean ± standard deviation of triplicate measurements and analyzed as one-way analysis of variance (sigmastat ver. 2.0). The significant differences between means were calculated by a one way analysis of variance (ANOVA) using dunnett multiple-range test at P<0.05.
RESULT AND DISCUSSION
A major lacuna in using herbal medicines is the lack of drug standardisation, information and quality control. With the ever-increasing use of herbal medicines worldwide and the rapid expansion of the global market for these products, the safety and quality of medicinal plant materials and finished herbal medicinal products have become a major concern for health authorities, pharmaceutical industries and the public. The present study deals with evaluation of Morus nigra seeds by assessing physical parameter and proximate analysis so that a systematic data could be established for its quality control.
Physical evaluation
The results for physical evaluation were depicted in Table 1. The residue remaining after incineration of plant material is the ash content or ash value, which simply represents inorganic salts, naturally occurring in plant material or adhering to it or deliberately added to it, as a form of adulteration. Seeds contained 5.553% total ash out of which 4.736% is acid soluble and remaining is acid insoluble. Total ash value is a diagnostic purity index. It represents both physiological ash and non-physiological ash. Physiological ash is derived from plant tissues due to biochemical processes while non-physiological ash consists of residue of the extraneous matter (such as sand, soil, etc.) adhering to plant samples itself. Physiological ash gets dissolved in the dilute acid while some of the non-physiological ash remains undissolved [20]. Carbonates, phosphates, nitrates, sulphates, chlorides and silicates of various metals which were taken up from the soil or environment constitute total ash [21]. Acid-insoluble ash is a part of total ash and measures the amount of silica present, especially as sand and siliceous earth in the samples. Lower and higher value of acid insoluble ash content indicates the magnitude of presence of oxalates, carbonates, phosphates, oxides and silicates respectively. Thus 0.817% of acid insoluble ash in Morus nigra seeds is indicative of the presence of high content of oxalates, carbonates, phosphates and oxides while low content of silicates. Water soluble ash (0.694%) content gives the crude estimate of the water soluble extractable matter present in the ash [22]. If the aqueous extract of crude shows biological activity the role of water soluble ash value is important. Exhausted powder may be used as adulterant for those drugs. Therefore, water-soluble ash value is quite reliable parameter to judge such type of adulteration. The Sulphated ash value of seeds was calculated to be 5.910%. Sulphated ash gives a more reliable ash Fig. for sample containing varying amount of volatile inorganic substances that may be lost at the ignition temperature used. During estimation of total ash there may be certain constituents like alkali chlorides, oxides and carbonates which may be volatile at that temperature and will be lost. In order to prevent these constituents from being volatilized and to obtain a more reliable ash value the sample is treated with sulphuric acid, due to which all the chlorides, oxides and carbonates are converted to sulphates and the ignition can be carried out at higher temperature [23]. Extractive value shows 6.651% alcohol soluble and 5.587% water soluble content seeds. The extracts obtained by exhausting crude drugs are indicative of approximate measures of their chemical constituents, further it also helps in selecting a suitable solvent, when exhaustive extraction is carried out [22]. In the lack of previous studies these parameters provide referential information for physical evaluation of Morus nigra seeds.
Table 1: Physical evaluation of Morus nigra seeds
| Parameter | Sub-Parameter | Results (%)* |
| Ash Value | Total Ash | 5.553 ± 0.75 |
| Acid Insoluble Ash | 0.817 ± 0.08 | |
| Acid Soluble Ash | 4.736 ± 0.13 | |
| Water Soluble Ash | 0.694 ± 0.19 | |
| Sulphated Ash | 5.910 ± 0.66 | |
| Extractive Value | Alcohol soluble | 6.561 ± 0.26 |
| Water soluble | 5.587 ± 0.92 |
* Results are expressed as mean of 3 values ± standard deviation
Proximate analysis
Proximate analysis plays a significant role in assessing the quality control of those medicinal herbs which are also used as “functional food.” The food that provides nutrition in addition to its therapeutic role and Morus nigra is one of them. The results of proximate analysis of Morus nigra seeds are illustrated in Table 2. The proximate analysis revealed moisture content of 5.356%, which is within the acceptable limits of about 6 to 15% for most vegetable drugs. Low moisture content reduces errors in the estimation of the actual weight of drug material, reduces components hydrolysis by reducing the activities of hydrolytic enzymes which may destroy the active components, and also reduces the proliferation of microbial colonies and therefore minimize the chance of spoilage due to microbial attack. The result demonstrated that seeds of Morus nigra are good source of protein, fat and crude fiber. The appropriate fiber content 5.662% shows its dietary importance. The high carbohydrate content 68.145% is beneficial since carbohydrate constitutes a major class of naturally occurring organic compounds that are essential for the maintenance of plant and animal life and also provide raw materials for many industries [24]. Available carbohydrate of the seeds was calculated to be 62.483%. Available carbohydrate represents that fraction of carbohydrate that can be digested by human enzymes, is absorbed and enters into intermediary metabolism. It does not include dietary fibre, which can be a source of energy only after fermentation. As compared to other herbal drugs seeds could also be reliable source of available carbohydrate content.
To best of our knowledge, no study on proximate analysis of Morus nigra seeds has so far been reported, so these values are novel for this plant and will surely help in an assessment of quality control of this plant.
Table 2: Proximate analysis of Morus nigra seeds
| Parameter | Results (%)* |
| Moisture Content | 5.356 ± 0.19 |
| Total nitrogen Content | 2.886 ± 0.59 |
| Crude Protein | 18.039 ± 0.67 |
| Crude Fat | 2.907 ± 0.06 |
| Crude Fiber | 5.662 ± 0.85 |
| Total Carbohydrate Content | 68.145 ± 0.62 |
| Available Carbohydrate Content | 62.483 ± 0.36 |
* Results are expressed as mean of 3 values ± standard deviation.
Nutritive value
The nutritive value of seeds was calculated using general Atwater factors and found to be 370.899 Kcal/100 gm. The nutritive value is suggestive that seeds are the excellent source of fat, carbohydrate, and protein; hence a good source of energy. The high nutritive value indicates that seeds of Morus nigra can be used as the formulation in various dietary supplements with promising nutritional attributes.
Extractive yield
Successive extraction of seeds with different solvents in increasing order of polarity yielded different extracts. The extractive yield (in % w/w) of extracts with their consistency after complete removal of the respective solvent is illustrated in Table 3. The maximum yield was captured in aqueous (21.133%) followed by petroleum ether (17.970%) extract respectively.
Table 3: Extractive yield of different extracts of Morus nigra seeds
| Extracts | Consistency | %Yield (w/w) |
| Petroleum Ether | Oily, Viscous | 17.970 |
| Ethyl Acetate | Semisolid | 2.068 |
| Ethanol | Semisolid, Sticky | 2.623 |
| Aqueous | Semisolid, Fluidy | 21.133 |
Phytochemical screening
The result for phytochemical screening of Morus nigra seed extracts was shown in Table 4. The result of phytochemical screening revealed that seeds contain a number of secondary metabolites like alkaloids, carbohydrates, glycosides, inulin, protein, amino acid, Steroids, triterpenoids, fixed oils, fats, phenolic group, flavonoids, gums and mucliages and naphthoquinones. The presence of these phytoconstituents suggests that the seeds of this plant might be of medicinal importance to pharmaceutical industries. Seeds are devoid of hydroxyanthraquinones. Ethanol and ethyl acetate extract contained maximum phytoconstituents. Secondary metabolites and other chemical constituents of medicinal plants account for their medicinal value [25] and the results of phytochemical screening are indicative for its therapeutic value and also for the use of this plant traditionally in a number of disorders.
Anti-microbial activity
In this study, extracts from seeds of Morus nigra was evaluated for antibacterial and antifungal activity by agar well diffusion method.
Anti-bacterial activity
Plate (1─4) and Plate (5─8) represent the antibacterial activity of standard drug (Ofloxacin) and Morus nigra seed extracts respectively. The results for antibacterial activity of Morus nigra seeds were summarized in Table 5 and compared with standard ofloxacin. Table 6 illustrates the antibacterial activity of each extracts in term of percentage inhibition relative to standard drug. Ethyl acetate extract was more promising and found to be highly active against all bacterial strains as compared to other extracts. Petroleum ether extract was inactive against gram positive while highly active against gram negative bacterial strains. Ethanol extract showed the zone of inhibition against S. aureus only while aqueous extract was only active against S. enteric. The excellent antimicrobial activity of ethyl acetate extract might be attributed to the presence of a number of complex secondary metabolite.
Table 4: Phytochemical screening of different extracts of Morus nigra seeds
Phytoconstituents and Test performed |
Extracts |
|||||
PE |
EA |
ET |
AQ |
|||
Alkaloids |
Mayer’s Test |
- |
- |
- |
- |
|
Wagner’s Test |
- |
- |
+ |
- |
||
Hager’s Test |
+ |
+ |
+ |
- |
||
Tannic acid Test |
- |
+ |
+ |
+ |
||
Carbohydrate |
Molisch’s Test |
- |
- |
+ |
+ |
|
Fehling’s Test |
- |
- |
+ |
+ |
||
Benedict’s Test |
- |
- |
- |
+ |
||
Selivanoff’s Test |
- |
- |
- |
+ |
||
Glycosides |
Anthraquinone |
Borntrager’s Test |
+ |
- |
- |
- |
Hydroxyanthraquinone |
- |
- |
- |
- |
||
Cardiac glycosides |
Keller-Killiani Test |
+ |
+ |
- |
- |
|
Legal’s Test |
- |
- |
- |
- |
||
Baljet’s Test |
- |
- |
- |
- |
||
Saponin glycosides |
Froth formation Test |
- |
- |
- |
+ |
|
Flavanol glycosides |
Mg and HCl reduction |
- |
- |
+ |
- |
|
Inulin |
- |
- |
+ |
- |
||
Protein |
Heat Test |
- |
- |
+ |
- |
|
Biuret Test |
- |
- |
+ |
+ |
||
Xanthoproteic Test |
- |
- |
+ |
+ |
||
Amino Acid |
Ninhydrin Test |
- |
- |
- |
+ |
|
Steroid/ Triterpenoid |
Salkowski Test |
+ (T) |
+ (S) |
+ (S) |
- |
|
Fixed oils and Fats |
Spot Test |
+ |
+ |
+ |
- |
|
Saponification Test |
+ |
+ |
+ |
- |
||
Flavonoids |
Shinoda Test |
- |
- |
+ |
- |
|
Alkaline reagent Test |
- |
- |
- |
- |
||
Zinc hydrochloride Test |
- |
- |
+ |
- |
||
Phenolic compounds and Tannins |
Lead Acetate Test |
- |
- |
+ |
+ |
|
Ferric chloride Test |
- |
- |
+ |
+ |
||
Test for Catechin |
- |
- |
- |
- |
||
Test for Chlorogenic acid |
- |
- |
- |
- |
||
Gums and Mucilage |
- |
- |
+ |
+ |
||
Naphthoquinone |
Juglone Test |
- |
+ |
+ |
+ |
|
Dam-Karrer Test |
- |
- |
- |
- |
||
+: Present, -: Absent, PE: Petroleum ether, EA: Ethyl acetate, ET: Ethanol, AQ: Aqueous, T: Triterpenoids, S: Steroids
Table 5: Antibacterial activity of Morus nigra seed extracts compared with Ofloxacin
Bacterial strain |
Zone of Inhibition in mm |
||||
Ofloxacin |
Petroleum Ether |
Ethyl Acetate |
Ethanol |
Aqueous |
|
Bacillus cereus |
27.033±0.55 |
- |
11.980±2.26 |
- |
- |
Staphylococcus aureus |
43.262±0.38 |
- |
12.890±0.69 |
9.050±0.99 |
- |
Salmonella enteric |
45.360±1.92 |
9.020±2.01 |
9.990±0.90 |
- |
9.050±0.65 |
Pseudomonas aeruginosa |
23.900±0.36 |
9.660±2.20 |
13.820±1.85 |
- |
- |
*Results are expressed as mean of 3 values ± standard deviation (-): No zone of inhibition
Table 6: Percentage antibacterial inhibition of Morus nigra seed extracts with respect to standard drug
Bacterial strain |
Percentage Inhibition (%) |
|||
Petroleum Ether |
Ethyl Acetate |
Ethanol |
Aqueous |
|
Bacillus cereus |
- |
44.316 |
- |
- |
Staphylococcus aureus |
- |
29.975 |
20.919 |
- |
Salmonella enteric |
19.885 |
22.024 |
- |
19.951 |
Pseudomonas aeruginosa |
40.418 |
57.824 |
- |
- |
The active components usually interfere with growth and metabolism of microorganisms in a negative manner [26]. Beside this the role of components present in small quantity cannot be nullified because crude extracts always represents a complex mixture of different chemical components; thus, it is difficult to reduce the antibacterial effect of the total extract to a few active principles.
|
|
| Plate–1 | Plate–2 |
|
|
| Plate–3 | Plate–4 |
| Plate. 1–4: Antibacterial activity of standard drug (Ofloxacin) | |
 |
 |
| Plate–5 | Plate–6 |
 |
|
| Plate–7 | Plate–8 |
| Plate 5–8: Antibacterial activity of Morus nigra seed extracts |
Anti-fungal activity
Plate (9─10) and Plate (11─12) represents the antifungal activity of standard drug (Fluconazole) and Morus nigra seed extracts respectively. The results for antifungal activity of Morus nigra seed extracts were illustrated in Table 7. Table 8 depict the anti-fungal activity of each extracts in term of percentage inhibition relative to standard drug. All the extracts demonstrated activity against both fungal strains. Ethyl acetate extract showed maximum anti-fungal activity for both strains, followed by ethanol extract. When compared with standard drug, extracts were several folds less active for both fungal strains. Generally, the use of synthetic anti-fungal drugs gives a more potent activity when compared to a complex mixture of components such as plant extracts. But one thing that always should be remembered that synthetic drugs have undesirable side effects as compared to the natural anti-fungal drugs of plant origin [27]. Again the anti-fungal potential of these extracts may be attributed to the presence of phenolic, flavonoid, terpenoids and other complex secondary. Metabolites.
Table 7: Antifungal activity of Morus nigra seed extracts compared with Fluconazole
Fungal strain |
Zone of Inhibition in mm |
||||
Fluconazole |
Petroleum Ether |
Ethyl Acetate |
Ethanol |
Aqueous |
|
Aspergillus flavus |
42.660±0.27 |
12.080±0.88 |
14.910±1.50 |
13.090±1.62 |
10.900±0.66 |
Candida albicans |
42.000±0.20 |
10.910±0.85 |
15.130±0.96 |
11.580±0.65 |
9.550±1.20 |
*Results are expressed as mean of 3 values ± standard deviation
Table 8: Percentage antifungal inhibition of Morus nigra seed extracts with respect to standard drug
Fungal strain |
Percentage Inhibition (%) |
|||
Petroleum Ether |
Ethyl Acetate |
Ethanol |
Aqueous |
|
Aspergillus flavus |
28.316 |
34.950 |
30.684 |
25.550 |
Candida albicans |
25.976 |
36.023 |
27.571 |
22.738 |
 |
|
| Plate–9 | Plate–10 |
| Plate 9–10: Antifungal activity of standard drug (Fluconazole) |
|
|
| Plate–11 | Plate–12 |
| Plate 11–12: Antifungal activity of Morus nigra seed extracts |
CONCLUSION
The present study was aimed to perform physical evaluation, proximate analysis and antimicrobial activity of Morus nigra seeds. Since this is the first report regarding these parameter and activity on seeds of this plant, so could be novel and provide referential information for correct identification and set up some parameters for quality control of Morus nigra seeds. All the parameter assessed lies within the permissible limit range as per herbal pharmacopoeia. Seeds are rich in protein, fat, fiber and carbohydrate which are indicative of its nutritive potential. Tremendous antibacterial and antifungal activity of seeds established a scientific proof for its traditional claim. Presence of bioactive phytoconstituents in seeds laid down a platform in search for a lead molecule that could be a potent antibacterial and antifungal agent of natural origin.
CONFLICT OF INTERESTS
Declared None
ACKNOWLEDGMENT
The authors are thankful to Department of chemistry, Gurukula Kangri Vishwavidyalaya, Haridwar, Uttarakhand, India for providing all necessary facilities to carry out the research work.
Authors heartily acknowledge Head, Department of Zoology and Environmental Sciences Gurukula kangri Vishwavidyalaya, Haridwar for providing laboratory facilities for microbiological studies.
REFERENCES
- Pandey CN, Raval BR, Mali S, Salvi H. Medicinal Plants of Gujarat. Gujarat Ecological Education and Research (GEER) Foundation, Gandhinagar; 2005. p. 1-410.
- Chakravarthy BK. Standardization of herbal products. Indian J Nat Prod 1993;9:23-6.
- Perez-Gregorio M, Regueiro J, Alonso-Gonzalez E, Pastrana-Castro L, Simal-Gandara J. Influence of alcoholic fermentation process on antioxidant activity and phenolic levels from mulberries (Morus nigra L.). LWT-Food Sci Tech 2011;44:1793-1.
- Sengul M, Ertugay MF, Sengul M. Rheological, physical and chemical characteristics of mulberry pekmez. Food Control 2005;16:73-6.
- Ahmad J, Farooqui, AH, Siddiqui TO. Morus nigra. Hamdard Med 1985;15:76-8.
- Kumar V, Chauhan S. Mulberry: Life enhancer. J Med Plants Res 2008;2(10):271-8.
- Diwedi SV. Bhavprakashnighantu. New Delhi (India): Motilal Banarasidas Publishers Private Limited; 2007.
- Indian Pharmacopoeia. The Indian Pharmacopoeia commission, central Indian Pharmacopoeial laboratory, Government of India, Ministry of health and family welfare, Ghaziabad, India; 2007;1:78-191.
- Singh D, Chhonkar PK, Pandey RN. Soil, plant & water analysis–A method manual. IARI, New Delhi; 1999.
- Horneck DA, Miller RO. Determination of total nitrogen in plant tissue. In: Kalra YP, editor. Handbook and Reference Methods for Plant Analysis, CRC Press, Taylor and francis Group; 1998. p. 75–83.
- Foss Analytical. The determination of nitrogen according to kjeldahl using block digestion and steam distillation. FOSS Analytical AB, Höganäs, Sweden. AN; 2003. p. 300.
- AOAC. Official methods of analysis. Association of analytical chemists, method, 954.02. Fat (crude) or ether extract in pet food. 18th ed. AOAC (Association of Official Analytical Chemists) Int., Gaithersburg, MD; 2005.
- AOAC. Official Methods of Analysis. Association of analytical chemists, method 920.39, Fat (crude) or ether extract in animal feed. 18th ed. AOAC (Association of Official Analytical Chemists) Int, Gaithersburg, MD; 2005.
- Foss Analytical. The determination of crude fibre (CF) in feed according to AOAC, ACCC and AOCS standards. FOSS Analytical AB, Hoganas, Sweden. AN; 2003. p. 3428.
- FAO. Food and agriculture organization of the United Nations, Rome. FAO Food energy–methods of analysis and conversion factors. Food Nut 2002;4725:3-6.
- Harborne JB. A Guide to Modern Techniques of Plant Analysis. London: Chapman and Hall; 1984.
- Kokate CK, Purohit AP, Gokhale SB. Pharmacognosy. 35 ed. Pune (India): Nirali prakashan; 2006.
- Perez C, Pauli M, Bazerque P. An antibiotic assay by the well agar method. Acta Biol Med Exp 1990;15:113-5.
- Paluri V, Ravichandran S, Kumar G, Karthik L, Rao KB. Phytochemical composition and in vitro antimicrobial activity of methanolic extract of Callistemon lanceolatus DC. Int J Pharm Pharm Sci 2012;4(2):699-2.
- Shellard EJ. Exercises in the evaluation of drugs and surgical dressings. 1st ed. Pitman Medical Publishing Co. Ltd; 1958.
- Kunle OF. Phytochemical and microbiological studies of the leaf of Lippia multiflora Mold, FAM. Verbanaceae. A Ph. D. dissertation, Ahmadu Bello University, Zaria; 2000.
- Kokate CK, Purohit AP, Gokhale SB. Pharmacognosy. 42nded. Pune (India); Nirali prakashan; 2008.
- Evans WC. Trease and Evans Pharmacognosy. 15th ed. Edinburgh: WB Saunders Publication; 2002.
- Shukla RK, Painuly D, Porval A, Shukla A. Proximate analysis, nutritive value, total phenolic content and antioxidant activity of Litchi chinensis Sonn. Nat Prod Indian J 2012;8:361-9.
- Varadarajan P, Rathinaswamy G, Asirvatahm D. Antimicrobial properties and phytochemical constituents of Rheo discolour. Ethnobotanical Leaflet 2008;12:841-5.
- Aboba OO, Etuwape BM. Antibacterial properties of some Nigerian species. Bioresou Community 2001;13:183-8.
- Iwu MM, Duncan AR, Okunji CO. New Antimicrobials of Plant Origin, In: Janick J, editor. Perspectives on new crops and new uses, Alexandria: ASHS Press; 1999. p. 459.